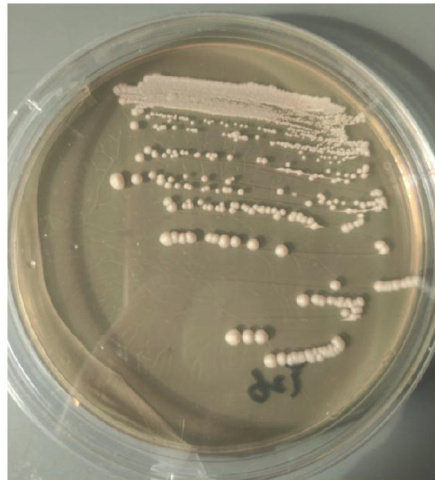

目录
快速导航-

植物生理与生物技术 | 植物MPKs及其与底物相互作用的研究进展
植物生理与生物技术 | 植物MPKs及其与底物相互作用的研究进展
-

作物栽培与设施园艺 | 中原二作区玉米/秋马铃薯不同行比对马铃薯生长的影响
作物栽培与设施园艺 | 中原二作区玉米/秋马铃薯不同行比对马铃薯生长的影响
-

作物栽培与设施园艺 | 不同种植密度对夏玉米植株性状、产量和纯收益影响
作物栽培与设施园艺 | 不同种植密度对夏玉米植株性状、产量和纯收益影响
-

作物栽培与设施园艺 | 香菇9608脱除LeV-HKB病毒后对子实体性状的影响分析
作物栽培与设施园艺 | 香菇9608脱除LeV-HKB病毒后对子实体性状的影响分析
-

农业经济与信息技术 | 基于多传感器数据的设施番茄地上、地下环境三维曲面模型分析
农业经济与信息技术 | 基于多传感器数据的设施番茄地上、地下环境三维曲面模型分析
-

农业经济与信息技术 | 片烟库存预测研究中组合时间序列模型的应用
农业经济与信息技术 | 片烟库存预测研究中组合时间序列模型的应用
-

农业经济与信息技术 | 基于MaxEnt模型预测烟草甲在全球的适生区
农业经济与信息技术 | 基于MaxEnt模型预测烟草甲在全球的适生区
-

农业经济与信息技术 | 基于高光谱数据结合BorutaShap_CatBoost算法的柑橘叶面积指数反演
农业经济与信息技术 | 基于高光谱数据结合BorutaShap_CatBoost算法的柑橘叶面积指数反演
-
贮藏与加工 | 一株酿酒酵母的筛选鉴定及其酿酒潜力研究
贮藏与加工 | 一株酿酒酵母的筛选鉴定及其酿酒潜力研究
-

贮藏与加工 | 欧季酒提质增效生产工艺优化研究
贮藏与加工 | 欧季酒提质增效生产工艺优化研究
-

土壤肥料与节水灌溉 | 氨基丁酸与有机肥料配施对连作马铃薯产量、品质和土壤活性的影响
土壤肥料与节水灌溉 | 氨基丁酸与有机肥料配施对连作马铃薯产量、品质和土壤活性的影响
-

园林绿化 | 武汉市悬铃木行道树的调查研究
园林绿化 | 武汉市悬铃木行道树的调查研究


 )T2(玉米/秋马铃薯 ?=1/2 )T3(玉米/秋马铃薯
)T2(玉米/秋马铃薯 ?=1/2 )T3(玉米/秋马铃薯  1/3)、T4(玉米/秋马铃薯
1/3)、T4(玉米/秋马铃薯  )、T5(玉米/秋马铃薯 =212 )、T6(玉米/秋马铃薯 =2/3 )、T7(玉米/秋马铃薯 =2/4 )共7个处理,分析比较不同行比间作下马铃薯生长环境、形态特征、产量的变化。结果表明:在各处理中,T2处理较T5处理产量显著增加 9.74% ,增产效果明显;马铃薯的株高随着玉米/秋马铃薯行比的减小而减小;各处理的土壤含水量的差异不显著;T2 处理较T7处理的日均土壤温度显著降低 8.9% ,日温差显著降低 46.7%. 综合分析,针对中原二作区特别是鲁西南地区玉米与秋马铃薯等带宽间作模式,1行玉米间作2行秋马铃薯的间作模式更有利于秋马铃薯的生长。
)、T5(玉米/秋马铃薯 =212 )、T6(玉米/秋马铃薯 =2/3 )、T7(玉米/秋马铃薯 =2/4 )共7个处理,分析比较不同行比间作下马铃薯生长环境、形态特征、产量的变化。结果表明:在各处理中,T2处理较T5处理产量显著增加 9.74% ,增产效果明显;马铃薯的株高随着玉米/秋马铃薯行比的减小而减小;各处理的土壤含水量的差异不显著;T2 处理较T7处理的日均土壤温度显著降低 8.9% ,日温差显著降低 46.7%. 综合分析,针对中原二作区特别是鲁西南地区玉米与秋马铃薯等带宽间作模式,1行玉米间作2行秋马铃薯的间作模式更有利于秋马铃薯的生长。 ,均方根误差分别为
,均方根误差分别为  。综上,该模型拟合程度较好,可为设施番茄种植中的环境变化研究提供理论支撑。
。综上,该模型拟合程度较好,可为设施番茄种植中的环境变化研究提供理论支撑。



















 登录
登录